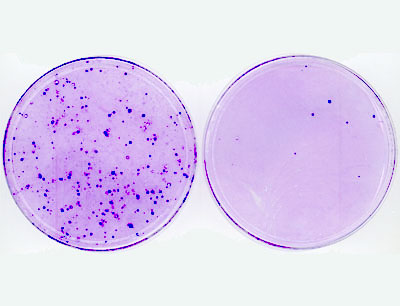

Krebs: Neues Angriffsziel für Medikamente
Beim Wachstum von Organismen durch Zellteilung nimmt das Gen Myc eine zentrale Stellung ein. Aus dem Myc-Gen wird ein Protein erzeugt, das als Transkriptionsfaktor die Expression von 15 Prozent aller menschlichen Gene reguliert. Mutiert dieses Gen zum Onkogen, wird die Zelle zu verstärktem Wachstum angetrieben und der natürliche Zelltod blockiert. Damit trägt das Gen entscheidend zur Entstehung vieler Krebserkrankungen bei. Pharmakologische Substanzen finden keine Angriffspunkte, da Myc keine eigene enzymatische Aktivität besitzt. Wissenschaftler aus aller Welt sind deshalb bemüht, alternative Wege zur Hemmung dieses Onkogens zu finden. Wissenschaftler um Klaus Bister und Markus Hartl vom Institut für Biochemie und vom Forschungszentrum für Molekulare Biowissenschaften (CMBI) der Universität Innsbruck könnten diesem Ziel nun einen entscheidenden Schritt näher gekommen sein.
Krankhaften Wachstumsschub einbremsen
Die Innsbrucker Forscher haben erstmals gezeigt, dass Myc die Expression des Gens BASP1 unterdrückt. Das hat sie dazu veranlasst zu überprüfen, welchen Effekt umgekehrt das BASP1 auf das Onkogen hat. In Zellexperimenten konnten sie den Nachweis erbringen, dass BASP1 die überschießende Funktion von Myc gezielt hemmen kann. „Die exakte biochemische Funktion von BASP1 ist heute noch unbekannt,“ erklärt Prof. Bister, „wir sehen in unseren Experimenten aber eindeutige Hinweise darauf, dass die durch das Onkogen Myc ausgelöste Zelltransformation mittels BASP1 gezielt blockiert werden kann und das Gen damit als Tumor-Unterdrücker wirkt.“ Diese Erkenntnis könnte in Zukunft die Entwicklung von neuen Arzneimitteln ermöglichen, die die Entstehung von Tumoren eindämmen.
Die Arbeitsgruppe um Bister veröffentlicht ihre Daten nun in der Online-Ausgabe der amerikanischen Fachzeitschrift Proceedings of the National Academy of Sciences (PNAS). Unterstützt wurden die Wissenschaftler vom österreichischen Wissenschaftsfonds FWF.